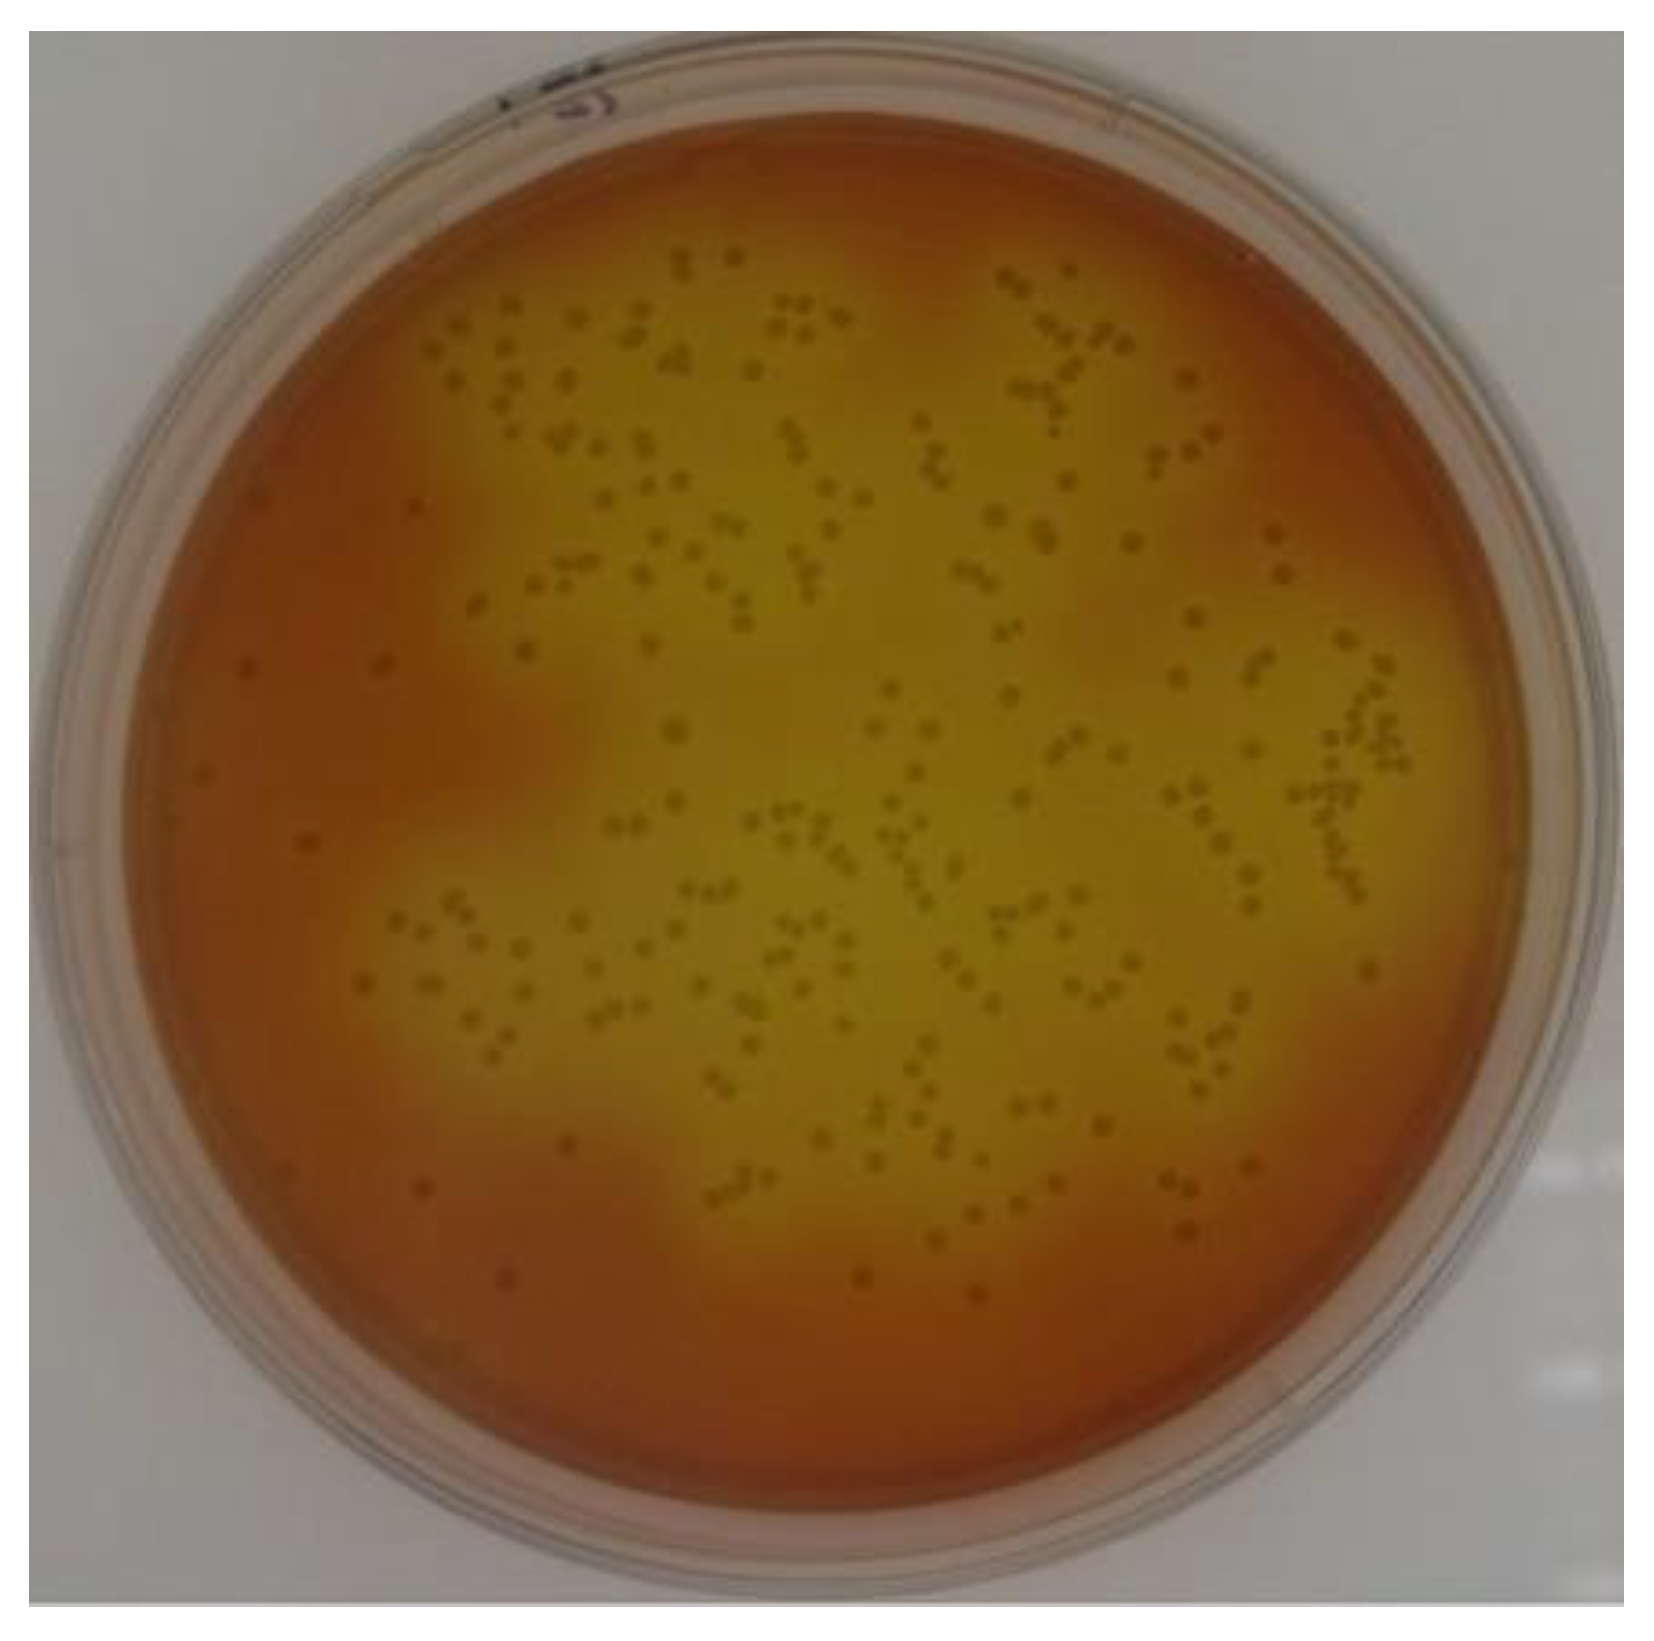
Molecules 28 01245 g001

1. Introduction
Steviol glycosides are natural low-calorie sweeteners with high sweetness isolated from the leaves of
Stevia rebaudiana. Steviol glycosides have attracted considerable attention from researchers and engineers in the food industry because they are natural, non-toxic, etc. [
1,
2,
3]. However, the drawbacks are also obvious; its taste is slightly bitter and astringent, and the onset of sweetness is slower than that of sucrose [
4,
5,
6].
Steviol glycosides are mixtures of diterpenoid glycosides, including stevioside (Stev), rebaudioside A (Reb A), rebaudioside D (Reb D), rebaudioside F (Reb F), rubusoside, and dulcoside A, and steviol aglycone is common in all the components [
7,
8,
9,
10]. The steviol aglycone has two active hydrogen molecules in the C13 hydroxyl and C19 carboxyl groups, which can perform intermolecular dehydration and glycogenesis reactions with the cyclic hemiacetal hydroxyl group of the sugar moiety to form various glycosidic compounds. Thus, steviol glycosides are formed on a common aglycone and steviol and differ only in the glycosidic constituents attached to C13 and/or C19 [
11,
12]. Studies have shown that the number of glucosyl groups attached to C13 and/or C19 considerably affects the taste profiles of steviol glycosides [
11,
12,
13]. The two major sweet components of steviol glycosides are Stev and Reb A [
13]. Stev was first discovered as the primary sweet component in
Stevia leaves; however, it exhibited a strong bitter aftertaste [
6,
14,
15,
16]. It has been established that the sweetness and taste qualities of Stev can be substantially improved via glycosylation, for instance, Reb A (addition of one glucosyl group on the C13 of Stev), Reb D (addition of one glucosyl group on the C19 of Reb A), and Reb M (addition of one glucosyl group on the C19 of Reb D; [
6]) taste better than Stev. Therefore, glycosylation is an approach for improving the taste profiles of steviol glycosides.
Cyclodextrin (CD) glucanotransferase (CGTase; EC 2.4.1.19) belongs to the α-amylase family 13 of glycoside hydrolases (GH13_2). With starch as the glycosyl donor, CGTase can transform steviol glycosides into glucosylated steviol glycosides [
12,
13,
17,
18,
19,
20,
21,
22]. The efficiency and components of the catalytic products of CGTase considerably affect the quality of glucosylated steviol glycosides. However, only a few CGTases are widely used in the market presently, leading to certain concerns, such as relatively fixed product components, low conversion rate, and high price, which substantially limit glucosylated steviol glycoside production.
Presently, Toruzyme
® 3.0 L from Novozymes is the most commonly used CGTase in the production of glucosylated steviol glycosides [
14,
23,
24]. Therefore, this study was conducted with Toruzyme
® 3.0 L as a control. Herein, a CGTase-producing
Alkalihalobacillus oshimensis strain was isolated from
Stevia planting soil in Shandong Province, China. Using mass spectrometry (MS)-based secretome profiling, a CGTase was identified and termed CGTase-13. With soluble starch as the glycosyl donor, CGTase-13 transformed Stev and Reb A into glucosylated steviol glycosides with high efficiency. In addition, the glucosylated steviol glycoside products produced via CGTase-13 tasted better than those produced via Toruzyme
® 3.0 L. The findings of this study will provide novel perspectives to establish a high-efficiency transglycosylation system for the catalysis of steviol glycosides into glucosylated steviol glycoside products with better taste.
2. Results
2.1. Strain Isolation
Among the 191 strains isolated from
Stevia planting soil in the Shandong Province, five strains exhibiting CGTase activity were further screened and cultured using Horikoshi medium plate. CGTases are unique enzymes that catalyze the conversion of starch to CD, which absorbs the dye contained in the Horikoshi media and forms a yellow halo zone. After assessing the transglycosylation ability of steviol glycosides via high-performance liquid chromatography (HPLC) analysis, an efficient CGTase-producing strain (wahahaMZJ-1) was selected for further studies. Based on physiological and biochemical characterization, 16s rDNA, and gyrB results, the isolated wahahaMZJ-1 strain producing CGTase was identified as
A. oshimensis. This strain was preserved at the China General Microbiological Culture Collection Center with CGMCC 23164. The colony morphology is shown in
Figure 1.
2.2. Characterization of the CGTase Transglycosylation Product
HPLC was used to detect the glucosylated steviol glycoside product (
Figure 2). The extracellular enzyme of
A. oshimensis wahahaMZJ-1 catalyzed various glucosylated steviol glycosides. Among them, the contents of the mono- and di-(α1-4)-glucosylated products were higher. Furthermore, compared with the products produced via Toruzyme
® 3.0 L, the products produced were different.
Because Reb D, Reb M, and their isomers are recognized as the components with better taste [
6,
25,
26,
27], a rough quantitative analysis was performed via ultrahigh-performance liquid chromatography-electrospray ionization–MS (UPLC–ESI–MS;
Table 1).
As shown in
Table 1, the peak areas of Reb D, Reb M, and their isomers catalyzed by the extracellular enzyme of
A. oshimensis were significantly higher than those of the products catalyzed by Novozyme
® 3.0 L.
There is a phenomenon of “glucosyl group loss from mother ion (glucosylated derivatives were partially resolved)” in the process of MS (e.g., Reb M and Reb M isomer will become Reb D and Reb D isomer if one glucosyl group is lost). Despite this, the products catalyzed by A. oshimensis extracellular enzyme exhibited higher contents of Reb D, Reb M, and their isomers than the products catalyzed by Toruzyme® 3.0 L. Therefore, it is speculated that a novel CGTase can be obtained from the extracellular enzyme for steviol glycoside modification, and the taste of the product is expected to be better than that produced via Toruzyme® 3.0 L.
2.3. Heterologous Expression and Transglycosylation Activity Detection
The 12 possible CGTases were detected via liquid chromatography-tandem MS (LC–tandem MS/MS), as shown in
Table S1.
The 12 CGTases were heterologously expressed and purified in
Escherichia coli. Soluble starch (20 g/L) and steviol glycosides (20 g/L) dissolved in sterile water were incubated with 12 purified enzymes (20 mg/L) at 40 °C, and 220 rpm for 24 h and transglycosylation activity was detected. Among them, five CGTases exhibited relatively good transglycosylation activity (
Table 2).
Owing to its good performance, CGTase-13 was selected for further study, and it was expressed heterologously in
Pichia pastoris GS115. The theoretical molecular weight of the CGTase-13 was 75.4 kDa. The recombinant CGTase-13 was analyzed by SDS–PAGE. The result is shown in
Figure 3.
2.4. Determination of Product Specificity
Soluble starch solution (20 g/L) prepared in 50 mM Na2HPO4/NaH2PO4 (pH 6.0) was incubated with the enzyme sample (20 mg/L) at 40 °C and 220 rpm for 18 h. The reaction product was diluted 10 times, and the concentrations of α-, β-, and γ-CDs were determined. The results revealed that the concentration of α-, β-, and γ-CDs were 0.152 ± 0.007, 0.322 ± 0.024, and 0.056 ± 0.005 mg/mL, respectively; hence, CGTase-13 belongs to β-CGTase.
2.5. Effects of Temperature, pH, Incubation Time, and Substrate Concentration on the Conversion Rate
It is easy to see that the optimum temperature was 40 °C (
Figure 4a). For Stev, in the pH range of pH 4–5, with the increase in pH, the conversion rate increased significantly. At pH 5–7, the conversion rate decreased slightly; however, the change was not obvious. When the pH exceeded 7, the conversion rate decreased significantly; thus, the optimal pH was 5 (
Figure 4b). For Reb A, in the pH range of pH 4–5, with the increase in pH, the conversion rate increased significantly. At pH 5–6, the conversion rate increased slightly. At pH 6–8, the conversion rate remained almost unchanged. When the pH exceeded 8, the conversion rate exhibited a downward trend; thus, the optimal pH was 6–8 (
Figure 4b). Therefore, according to the change range of the Stev and Reb A conversion rates, pH 6–7 was selected as the optimal pH.
For Stev, the conversion rate increased with the extension of reaction time within 0–6 h and did not change much after 6 h. For Reb A, the conversion rate increased rapidly with an increase in time from 0 to 10 h and slowly with an increase in time from 10–18 h. After 18 h, the conversion rate remained almost unchanged. Therefore, 18 h was selected as the optimum incubation time (
Figure 4c).
Within the concentration range of 10–50 g/L, the conversion rates of Stev and Reb A gradually increase with an increase in soluble starch concentration. As the maximum solubility of the soluble starch used was ~50 g/L, it is impossible to continue to increase its concentration. Thus, 50 g/L was selected as the optimal concentration of soluble starch (
Figure 5a).
Within the concentration range of 4–8 g/L, with an increase in steviol glycosides concentration, the Stev conversion rate increased slightly, whereas that of Reb A decreased slightly. When the steviol glycoside concentration exceeded 8 g/L, the conversion rates of Stev and Reb A exhibited a downward trend. Considering that the concentration of steviol glycosides used in actual production is generally ≥10 g/L, and the conversion rate of Stev and Reb A decreases by ≤5% when 8 g/L is compared with 12 g/L, 10 g/L was selected as the optimal concentration of steviol glycosides (
Figure 5b).
Under optimum conditions, the conversion rates of Stev and Reb A reached 86.1% and 90.8%, respectively.
2.6. Sensory Profiles of Enzymatically Modified Steviol Glycosides
The results of the sensory analysis are shown in
Figure 6. Compared with the products produced by Toruzyme
® 3.0 L, the glucosylated steviol glycoside product produced by CGTase-13 exhibited weaker astringency and unpleasant taste, faster sweetness onset, stronger sweetness intensity, and higher overall preference. The overall preference score of the CGTase-13 catalytic product was 71.3, and that of the Toruzyme
® 3.0 L product was 68.5. Thus, CGTase-13 improved the edulcorating quality of enzymatically modified steviol glycosides.
3. Discussion
Compared with steviol glycosides, an improvement in sweetness quality was observed in mono- and di-(α1-4)-glucosylated products. However, excessive glycosylation can affect the taste, such as decreasing sweetness and increasing bitterness [
14,
23]. Nevertheless, the number of transferred glucosyl groups of CGTase was random to some extent. Transglucosylation reactions yielded a mixture of mono- to multiple-(α1-4)-glucosylated products. Some studies have attempted to enhance the content of mono- and di-glucosylated products through control reaction conditions [
14,
23,
28]. The UPLC–ESI–MS results revealed that the contents of mono- and di-glucosylated products catalyzed by the extracellular enzyme of A. oshimensis were significantly higher than those of the products catalyzed by Toruzyme
® 3.0 L. Therefore, it was speculated that there might be a novel efficient CGTase in the extracellular enzyme. Furthermore, there was a potential chance for improving the sensory profiles of steviol glycosides.
Numerous studies have employed CGTase alongside steviol glycosides as acceptor substrates to improve the gustatory characteristics of steviol glycosides [
5,
23]. The selection of the donor substrate is very important for the quality of products. CDs and starches provide the best transglucosylation yield [
29]. Herein, CGTase-13 derived from A. oshimensis CGMCC 23164 was first identified, characterized, and applied for the transglycosylation of steviol glycosides using soluble starch as the donor substrate. In
Table 3, a higher glucosylation rate was reported than in the literature. Considering the well-described mechanisms of transglycosylation activity and substrate specificity of CGTases, it is expectable that the transglucosylated products reported herein are based on the exclusive transfer of (α1-4)-glucose residues to the C-19-carboxyl and/or C-13 hydroxyl groups [
10,
14].
To investigate the impact of modification, a sensory analysis was conducted using Toruzyme
® 3.0 L as a control, consistent with the literature [
14,
23,
24]. Compared with the product produced by Toruzyme
® 3.0 L, the glucosylated steviol glycoside product produced by CGTase-13 exhibited weaker astringency and unpleasant taste, faster sweetness onset, and stronger sweetness intensity. However, there remain some deficiencies in the aftertaste, such as a bitter taste, which warrant further improvement. This behavior resembles the results of Abelyan et al. [
30], who, despite the effectiveness of transglycosylation, did not completely remove the bitterness and residual aftertaste in steviol glycosides modified with CGTases [
12,
30]. Thus, the overall preference for glucosylated steviol glycosides catalyzed by CGTase-13 was higher than that of the product catalyzed by Toruzyme
® 3.0 L. This indicates that CGTase-13 has obvious advantages compared with Toruzyme
® 3.0 L, thereby providing a novel option for producing glucosylated steviol glycosides, and has great potential for industrial applications.
Prior studies have established that coupling and disproportionation activities are directly associated with transglycosylation activity [
32]. We selected CGTase-13, CGTase-15, and CGTase-7, which exhibit strong, medium, and weak transglycosylation abilities, respectively, and measured the coupling, disproportionation, hydrolysis, and cyclization activities of each enzyme. This established the degree of correlation between the strength of the transglycosylation ability of the enzyme and coupling, disproportionation, hydrolysis, and cyclization activities.
Table 4,
Table 5,
Table 6 and
Table 7 present a tabulation of our results. The coupling activity of the CGTases in the descending order was CGTase-15 > CGTase-13 > CGTase-7. The disproportionation activity of the CGTases is in the descending order was CGTase-15 > CGTase-13 > CGTase-7. The hydrolysis activity of the CGTases in the descending order was CGTase-13 > CGTase-15 > CGTase-7 (all three CGTases exhibited weak hydrolytic activity). The cyclization activity of the CGTases in the descending order was CGTase-15 > CGTase-13 > CGTase-7. No correlation was found between the strength of the transglycosylation ability of the enzymes and any of the four reactions that were studied. We suspect that these four reactions jointly affect transglycosylation activity in a complex manner. It has already been established that the transglycosylation reaction does not include the substrates involved in the coupling and disproportionation activities; hence, our data may not reflect the true process of the transformation of steviol glycosides to glucosylated steviol glycosides.
4. Materials and Methods
4.1. Strain Isolation and Identification
Strain isolation and identification were adapted from Yu et al. [
28], with minor modifications. The samples from the soil where
Stevia was planted were collected from the Shandong Province (China) and diluted in a sterile dilution solution (0.9% saline). The aliquots were subsequently carefully positioned onto a Horikoshi medium plate and incubated for 3 days at either 28 °C or 37 °C. The isolates that produced CDs formed yellow halo zones. Once the isolates were definitively confirmed to secrete CGTases, the transformed products of steviol glycosides were analyzed via HPLC assays.
To identify each strain, each 16S rRNA gene sequence was amplified via polymerase chain reaction using the primer 27F/1492R (27F: 5′-AGAGTTTGATCCTGGCTCAG-3′ and 1492R: 5′-GGTTACCTTGTTACGACTT-3′). The amplicons obtained were sequenced, and the 16S rRNA gene sequences were aligned with the sequences from GenBank (
http://www.ncbi.nlm.nih.gov/genbank/index.html, accessed on 10 February 2021.).
The 16S rRNA gene sequence of the strain was registered in GenBank nucleotide sequence databases with the accession number OP060998. The isolated strain was identified and deposited at the China General Microbiological Culture Collection Center with the strain number CGMCC 23164.
4.2. Protein Identification Using LC-Tandem MS (MS/MS)
Protein identification was performed at the APTBIO. Protein bands (70–100 kDa) were excised from the sodium dodecyl sulfate-polyacrylamide gel electrophoresis (SDS-PAGE) gel. A gel trypsin digestion method was performed to purify and prepare the gel piece (cut from an SDS-PAGE gel) before LC-MS/MS analysis.
The peptides were separated via EASY nLC and analyzed via MS using Q-Exactive (Thermo Scientific, Waltham, MA, USA). For LC analysis, separation was performed using a Thermo Scientific EASY column (2 cm × 100 μm, 5 μm C18) pre-column, followed by a Thermo Scientific EASY column (75 μm × 100 mm, 3 μm C18) at a flow rate of 300 nL/min. Full-scan MS spectra (m/z 300–1800) were acquired in the positive ion mode. MS files were searched against the Uniprot database (
http://www.uniprot.org/, accessed on 7 May 2021.) using MaxQuant. Proteins were considered positively identified when they were identified with at least two tryptic peptides per protein. The false discovery rate was 1% for both peptides and proteins.
4.3. Heterologous Expression and Purification
The cDNA sequences of CGTases were codon-optimized according to E. coli codon bias and further synthesized and cloned in pET-28a(+) via GENEWIZ (Suzhou, China). The cDNA sequences of CGTase-13 were also codon-optimized according to P. pastoris codon bias and further synthesized and cloned in pPIC9K via GENEWIZ. The sequence of CGTase-13 optimized for E. coli was submitted to GenBank and assigned the temporary accession number OP095271. The sequence of CGTase-13 optimized for P. pastoris was submitted to GenBank and assigned the temporary accession number OP095272.
4.3.1. Heterologous Expression and Purification in E. coli
The verified plasmids harboring the desired genes were transformed into E. coli BL21 (DE3) competent cells for expression. To induce expression, 0.1 mM IPTG was added to the media. After incubation, the cells were harvested via centrifugation (4500× g for 10 min). The harvested cells were suspended in sodium phosphate buffer (20 mM sodium phosphate, 200 mM NaCl, and 20 mM imidazole; pH 7.4). The cells were lysed on an ice bath via sonication, followed by centrifugation at 48,400× g for 30 min at 4 °C to remove insoluble cell debris. The recombinant proteins were purified via fast protein LC on an ÄKTA purifier equipped with 5 mL HisTrap affinity columns (GE Healthcare, Freiburg, Germany). The columns were equilibrated with binding buffer (20 mM sodium phosphate, 200 mM NaCl, and 20 mM imidazole; pH 7.4) at a flow rate of 2.5 mL/min. A 30 mL sample was loaded into the first column and extensively washed with binding buffer for five column volumes. The columns were then eluted with elution buffer (20 mM sodium phosphate, 200 mM NaCl, and 500 mM imidazole; pH 7.4). The purified enzymes were collected, and the elution buffer was replaced with protein buffer (50 mM sodium phosphate, pH 7).
4.3.2. Heterologous Expression in P. pastoris
The verified plasmid was digested using the restriction enzyme SacI and transformed into P. pastoris GS115 via lithium chloride transformation. The transformants were selected, cultured in 25 mL BMGY media, and incubated at 28 °C until the density at 600 nm (OD600) reached a value of 2–6. The transformants were centrifuged at 4000× g for 5 min to collect the cells, which were then inoculated into 100–200 mL buffered methanol complex media (BMMY). Then, 1% (v/v) methanol was added at 24 h intervals to induce the expression of the heterologous protein. After 4 days of induction, the cell cultures were centrifuged at 10,000× g for 5 min at 4 °C, and the supernatant was collected.
4.4. Transformation of Steviol Glycosides with CGTase
Strain isolation and identification were adapted from Yu et al. [
28], with minor modifications. Steviol glycosides (2 g) and soluble starch (2 g) were dissolved in 100 mL sterile water and divided into 2 mL centrifuge tubes (1 mL/tube). CGTase (20–21.2 mg/L) was added to the reaction solution, and the mixture was stored in a flask at 28–50 °C for 24 h to perform the reaction.
The conversion rate was calculated as follows [
23,
28]:
where
Co/
Co′ is the initial
Stev/
Reb A concentration, and
Ct/
Ct′ is the detected
Stev/
Reb A concentration after the reaction.
The reaction mixture was monitored via HPLC (LC1200; Agilent Technologies, Inc., Santa Clara, CA, USA, and Waters Alliance e2695; Waters Corporation, Milford, MA, USA). The chromatographic column used for screening the strains was SB-C18 (4.6 × 250 mm; Agilent Technologies). Other transglycosylation reactions used Hypersil NH2 column (4.6 × 300 mm; Dalian Elite Analytical Instruments Co., Ltd., Dalian, China) for detection.
4.5. UPLC-ESI-MS
The UPLC-ESI-MS analysis was conducted using Waters Acquity UPLC-Xevo TQ MS. The UPLC conditions are presented in
Table 8.
The MS parameters were polarity: ES-, full-scan mode, capillary: 3.5 kV, cone: 19 V, source temperature: 150 °C, desolvation temperature: 550 °C, cone gas flow: 60 L/h, and desolvation gas flow: 700 L/h.
4.6. Determination of Product Specificity
A 20 g/L soluble starch solution prepared in 50 mM Na2HPO4/NaH2PO4 (pH 6.0) was incubated with the enzyme sample (20 mg/L) at 40 °C and 220 rpm for 18 h. The reaction was quenched via incubation in a boiling water bath for 10 min. The reaction product was diluted 10 times, filtered through a 0.22-μm membrane, and analyzed using an evaporative light-scattering detector Alltech 3300 (1000254412; Waters Corporation).
The concentrations of α-, β-, and γ-CDs in the final sample were determined via UPLC using an Acquity BEH phenyl column (2.1 × 100 mm, 1.7 µm; Waters) and eluted with a methanol/water ratio of 1:99 at 0.3 mL/min.
4.7. Effects of Temperature, pH, Incubation Time, and Substrate Concentration on the Conversion Rate
Soluble starch (20 g/L) and steviol glycosides (20 g/L) dissolved in 50 mM Na2HPO4/NaH2PO4 (pH 6.0) were incubated with the enzyme sample (20 mg/L) at different temperatures (20 °C, 25 °C, 30 °C, 40 °C, and 50 °C) and 220 rpm for 24 h. The conversion rate was measured and calculated as described above.
The following buffers were used to evaluate the effect of pH on the conversion rate: 50 mM sodium acetate/acetic acid (pH 4–6), 50 mM Na2HPO4/NaH2PO4 (pH 6–8), and 50 mM Tris-HCl (pH 8–9.8). Soluble starch (20 g/L) and steviol glycosides (20 g/L) dissolved in a different pH buffer were incubated with the enzyme sample (20 mg/L) at 40 °C, 220 rpm for 24 h. The conversion rate was measured and calculated as described above.
Soluble starch (20 g/L) and steviol glycosides (20 g/L) dissolved in sterile water were incubated with the enzyme sample (20 mg/L) at 40 °C and 220 rpm for 0–24 h. The conversion rate was measured and calculated as described above.
Soluble starch (10, 20, 30, 40, and 50 g/L) and steviol glycosides (10 g/L) dissolved in sterile water were incubated with the enzyme sample (20 mg/L) at 40 °C and 220 rpm for 18 h. The conversion rate was measured and calculated as described above.
Soluble starch (20 g/L) and steviol glycosides (4, 8, 12, 16, and 20 g/L) dissolved in sterile water were incubated with the enzyme sample (20 mg/L) at 40 °C and 220 rpm for 18 h. The conversion rate was measured and calculated as described above.
4.8. Sweetness and Taste Evaluation via Sensory Methodologies
Sensory analysis was conducted by Zhucheng Haotian Pharmaceutical Co., Ltd., Zhucheng, Shandong. The experiments for sensory analysis were performed in a test room at a temperature of <30 °C. Eleven supertasters were recruited and requested not to eat or drink during the hour preceding testing, not to eat spicy foods during the previous day before each test, and not to use perfume on the day of testing. All stimuli were tested using a mouth sip-and-spit procedure. Each participant was provided with a cup of water. Participants were instructed to rinse their mouths between each sample and wait at least 2 min before continuing.
The evaluated samples were provided as solutions and included enzymatically modified steviol glycosides (product transformed by CGTase-13, 500 ppm) and enzymatically modified steviol glycosides (product transformed by Toruzyme®, 3.0 L, 500 ppm). Blind samples were provided to all the panelists for the sensory evaluation.
4.9. CGTase Activity Assays
The method to assess the disproportionation activity of the CGTases was adapted with minor modifications from Kong et al. [
33]. The reaction conditions were optimized. The activity assay was completed under optimum conditions using 4-nitrophenyl-α-D-maltoheptaoside-4-6-O-ethylidene (EPS) and maltose as substrates. One unit of disproportionation activity was defined as the amount of CGTase required to convert 1 μM of EPS/min.
The method to assess the coupling activity of the CGTases was adapted with minor modifications from van der Veen et al. [
34]. The reaction conditions were optimized. The activity assay was completed under optimal conditions using CD (α-, β-, γ-CD, respectively) and methyl α-D-glucopyranoside (M α-DG) as substrates. One unit of coupling activity was defined as the amount of CGTase required to couple 1 μM CD to M α-DG/min.
The method to assess the hydrolysis activity of the CGTases was adapted with minor modifications from Kong et al. [
33]. The reaction conditions were optimized. The activity assay was completed under optimal conditions, and the hydrolysis activity was calculated from the difference between the quantity of reducing sugar produced by the hydrolysis reaction at 5 and 1 h. One unit of hydrolysis activity was defined as the quantity of CGTase required to produce 1 μM of maltose/min.
The method to assess the cyclization activity of the CGTases was adapted with minor modifications from previously described studies [
35,
36] under optimal conditions; γ-CD was not detected owing to producing an undetectable yield. One unit of cyclization activity was defined as the amount of CGTase required to produce 1 μM of α-CD or β-CD/min.
All activity data represents the mean value calculated from the results of three independent determinations.